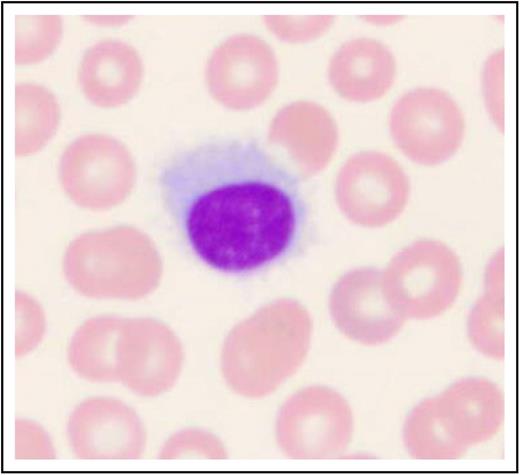
Figure 1. Histologic image of a hairy cell. Wright-Giemsa stained smear of peripheral blood. This image was obtained by using a UPlanFL 100 Olympus objective oil immersion lens. The image was obtained by using an MTI 3 CCD camera (DAGE-MTI Inc.) with PAX-it 2.0 acquisition software (MIS).

Abstract
Hairy cell leukemia is an uncommon hematologic malignancy characterized by pancytopenia and marked susceptibility to infection. Tremendous progress in the management of patients with this disease has resulted in high response rates and improved survival, yet relapse and an appropriate approach to re-treatment present continuing areas for research. The disease and its effective treatment are associated with immunosuppression. Because more patients are being treated with alternative programs, comparison of results will require general agreement on definitions of response, relapse, and methods of determining minimal residual disease. The development of internationally accepted, reproducible criteria is of paramount importance in evaluating and comparing clinical trials to provide optimal care. Despite the success achieved in managing these patients, continued participation in available clinical trials in the first-line and particularly in the relapse setting is highly recommended. The Hairy Cell Leukemia Foundation convened an international conference to provide common definitions and structure to guide current management. There is substantial opportunity for continued research in this disease. In addition to the importance of optimizing the prevention and management of the serious risk of infection, organized evaluations of minimal residual disease and treatment at relapse offer ample opportunities for clinical research. Finally, a scholarly evaluation of quality of life in the increasing number of survivors of this now manageable chronic illness merits further study. The development of consensus guidelines for this disease offers a framework for continued enhancement of the outcome for patients.
Background
Hairy cell leukemia (HCL) is an uncommon chronic B-cell leukemia initially described by 2 independent investigators who established this as a distinct clinical entity.1,2 Although the initial term describing this disease was leukemic reticuloendotheliosis, the cell of origin was established to be a mature B cell.3 In 2008, the World Health Organization) determined that the classic form of hairy cell leukemia (HCLc) should be recognized as separate from the rarer variant of this disease called hairy cell leukemia variant (HCLv).4 The observation that a specific mutation, BRAFV600E, is present in the overwhelming majority of patients with HCLc and absent in HCLv validates the clinical observation that HCLv follows a different clinical course and response to therapy.5,6 Recently, Chung et al7 showed that hematopoietic stem cells from the bone marrow of patients with HCLc expressing the BRAFV600E mutation have self-renewal potential. The BRAFV600E mutation was also shown to play a key role in shaping the specific molecular signature, morphology, and antiapoptotic behavior of HCL.8 Molecular and genomic studies identify prognostic factors in HCL that are associated with different responses to therapy.9-13 The consistent application of these respective prognostic parameters may have an impact on the optimal management of patients.
The introduction of the purine nucleoside analogs (cladribine and pentostatin) either alone or in combination with an anti-CD20 monoclonal antibody secured durable complete responses.14-21 Nevertheless, patients relapse and require additional therapy. Substantial variability has been introduced into how these agents are administered.22-24 Mature data regarding long-term follow-up has shown the effectiveness of the purine analogs delivered either by continuous infusion or subcutaneous injection (eg, cladribine) or by intravenous administration (pentostatin).22,25-28 Because more patients are treated with alternative regimens, comparison of results will require general agreement on definitions of response, relapse, and methods of determining minimal residual disease (MRD). The development of internationally accepted, reproducible criteria is of paramount importance in evaluating and comparing clinical trials.29 In an effort to clarify the approach to diagnosis, the criteria for initiating therapy, and the selection of therapy followed by an assessment of response, the Hairy Cell Leukemia Foundation convened an international conference to establish consensus on managing patients with HCL. In addition, recommendations were considered for how to approach the patient with relapse who requires re-treatment. The unresolved but important question on how patients with active infection should best be managed and recommendations for incorporating prophylaxis for infection were discussed. Hopefully, the adoption of consensus guidelines will enable international experts to continue making progress toward improving the quality of life of patients despite the diagnosis of leukemia.
Establishing the diagnosis
Patients often present with symptoms of fatigue and infection.1,2,30,31 Although patients in the past often presented with an enlarged spleen (approximately 90%), this finding appears to be much less frequent as a result of earlier detection of disease. More commonly, patients present because of incidental findings of pancytopenia.30,31 The initial evaluation should include careful review of the peripheral blood smear with a differential count; monocytopenia is a relatively sensitive and specific manifestation of HCLc. Leukemic cells are often rare. Hairy cells are medium in size with moderately abundant pale blue cytoplasm, reniform nuclei, open chromatin, absent nucleoli, and a characteristic serrated cytoplasmic border (Figure 1). In Table 1, the recommended initial work-up is presented for HCL and other clinical entities that may mimic this disease (eg, HCLv, splenic marginal zone lymphoma, and splenic diffuse red pulp small B-cell lymphoma).
Histologic image of a hairy cell. Wright-Giemsa stained smear of peripheral blood. This image was obtained by using a UPlanFL 100 Olympus objective oil immersion lens. The image was obtained by using an MTI 3 CCD camera (DAGE-MTI Inc.) with PAX-it 2.0 acquisition software (MIS).
Histologic image of a hairy cell. Wright-Giemsa stained smear of peripheral blood. This image was obtained by using a UPlanFL 100 Olympus objective oil immersion lens. The image was obtained by using an MTI 3 CCD camera (DAGE-MTI Inc.) with PAX-it 2.0 acquisition software (MIS).
The immunophenotypic profile of the leukemic cells is critical for establishing this diagnosis. Immunophenotypic characterization of the peripheral blood mononuclear cells reveals light chain restriction of either κ− or λ-expressing populations of B cells. The characteristic immunophenotype of CD19+, CD20+, CD11c+, CD25+, CD103+, CD123+ co-expressing cells confirms the diagnostic features of HCLc.3,32 These cells are intensely stained for CD200 expression33,34 but negatively stained for CD27 antigen. In contrast, leukemic cells in patients with HCLv are most often negative for CD25 and CD123, and most of these patients will not be monocytopenic.32,35
A trephine bone marrow biopsy and aspirate are important for understanding the extent of bone marrow infiltration. At diagnosis, a successful bone marrow aspirate is often not attainable because of a dry tap, in which extensive fibrosis precludes the ability to obtain a cellular aspirate. Approximately 10% of patients will also have a hypocellular bone marrow biopsy at diagnosis reflecting a decrease in normal hematopoiesis.36 The extent of bone marrow leukemic cell involvement is often more accurately assessed with immunohistochemical stains. Immunohistochemical stains for CD20, annexin-1,37 and VE1 (a BRAFV600E stain) will help establish the diagnosis and provide an accurate assessment of the degree of bone marrow infiltration by leukemic cells.36,38,39 Demonstration of the BRAFV600E mutation could also be important for those who do not respond to standard therapy or have multiple relapses.40-45 Inhibitors of BRAFV600E have provided responses in patients who are resistant to standard therapy.46 Consequently, it is now recommended that all patients with HCL be evaluated for this mutation by using a sensitive molecular assay that can detect the often few (<10%) leukemic cells present in the peripheral blood or in bone marrow aspirates diluted with blood as a result of dry tap.47 It is important to note that, in order to avoid false-negative results, highly sensitive techniques (eg, allele-specific polymerase chain reaction47 or next-generation sequencing) should be preferred over less sensitive techniques (eg, Sanger sequencing, pyrosequencing, or melting curve analysis). If access to sufficient leukemic cells or to highly sensitive molecular techniques for genomic profiling is not readily achievable, then application of immunohistochemical stain (eg, VE1) to the bone marrow biopsy may enable detection of this mutation.38,39
Treatment
Although the majority of patients with HCL require treatment, a small number (about 10%) may not require immediate therapy and may be closely observed until therapy is needed.48 In general, the therapeutic agents used to treat HCL are quite effective, but they are immunosuppressive. After the administration of a purine nucleoside analog, there is a further decline in neutrophils before recovery. Initiating therapy before the blood parameters have declined to a dangerous level or before a patient has an active infection is advised.
Patients should be treated if they have symptoms from the disease or if the hematologic parameters are declining. In general, the hematologic parameters indicating a need for treatment include at least one of the following: hemoglobin <11 g/dL, platelet count <100 000/µL, or absolute neutrophil count <1000/µL.20,49 Although these parameters serve as a guide for therapy, they indicate that bone marrow function is compromised and requires intervention. However, some patients with moderate asymptomatic pancytopenia may remain progression-free for many years without therapy. Others present with profound pancytopenia which may be accompanied by massive splenomegaly. Symptomatic splenomegaly may serve as an indication for treatment.
Primary nucleoside analog induction therapy for HCL involves either cladribine or pentostatin.20,49 The administration of cladribine has been effective in several different schedules and by different routes (eg, intravenous continuous infusion for 7 days, intravenous infusion over 2 hours on a 5-day regimen, or alternatively subcutaneously on a once-per-day or once-per-week regimen (Table 2). Subcutaneous administration reduces cost as well as the inconvenience and adverse effects associated with intravenous treatment. Pentostatin is administered intravenously in an outpatient setting once every other week to those with near-normal renal function.50 Both agents administered on 1 of these schedules appear to be equally effective.3,15,51 The choice is determined by physician preference or patient convenience with no benefit to support one over the other.
Cladribine is more myelosuppressive when the entire course of therapy is administered over a week. Pentostatin may also be myelosuppressive, but the schedule of administration enables dose titration to reduce the depth and the duration of myelosuppression. Cladribine is not used in patients who have an active infection. In the initial studies of this highly effective agent, patients with uncontrolled infection were excluded.52,53 In contrast, pentostatin has been used effectively in patients with an active infection,50,54 and reduced doses have been used in patients who are likely to have complications from prolonged myelosuppression. In the absence of infection, cladribine is probably the agent that is used most often. Both pentostatin and cladribine are very immunosuppressive.
Cladribine is administered on a defined schedule and is most often completed with the initial course of treatment as either a 5-day or weekly plan for 6 weeks or a 7-day continuous intravenous infusion. Pentostatin is administered on alternate weeks until hematologic parameters have nearly normalized and splenomegaly has disappeared on physical examination.20,49,50,55,56 Patients should be followed closely for evidence of fever or active infection, and routine blood counts should be obtained until recovery.
One of the most challenging clinical situations involves the patient with HCL who requires treatment but has an active infection.3 Attempts to control the infection should be pursued before beginning treatment with the purine nucleoside analog.15,55 If it is not possible to control the infection and antileukemia therapy is needed, then a decision regarding primary therapy requires the use of either a purine analog or interferon alpha.57 Vemurafenib has been reported to be effective in patients with hairy cell leukemia in relapse after primary purine analog therapy. The recent observation of the ability of vemurafenib to increase peripheral blood counts and thus enhance the control of infection is very encouraging and requires validation in clinical trials for those patients with an active infection.58
Assessment of response
Assessment of response involves inspection of hematologic parameters, complete physical examination, including an evaluation of spleen size, and then a bone marrow biopsy to determine whether normal hematopoiesis has been established with eradication of the leukemia. Assessment of the completeness of the response may provide guidance regarding the future clinical course. Patients who have the longest disease-free interval have usually achieved a complete remission. An assessment of response is an important part of care. In general, it is recommended that a follow-up bone marrow biopsy after cladribine therapy should be delayed for 4 to 6 months after drug administration is complete. Following purine analog therapy, there can be delayed and continuing improvement. The bone marrow biopsy after pentostatin therapy is usually performed after a clinical response that includes near normalization of hematologic parameters. Administering 2 consolidation doses of pentostatin after induction therapy is completed has been the general practice, but this consolidation has not been proven to be necessary. In patients being treated with pentostatin, failure to obtain clinical evidence of an objective response by 6 months indicates that it is time to select another therapeutic approach. In contrast, patients who show objective evidence of a response by 6 months were treated for up to a year in an attempt to achieve an optimal response.50
Complete response
Accumulated data support that achievement of a complete response is associated with longer duration of disease-free interval.14,26,27,51 Although this disease is not curable with current therapy, patients can achieve durable remissions that do not require continued treatment unless symptomatic relapse occurs.59 Because the achievement of complete remission has been the goal of most therapeutic investigations, it is essential that a complete response be carefully defined.49
Patients in complete response should have near normalization of peripheral blood counts: hemoglobin >11g/dL (without transfusion), platelets >100 000/µL, and an absolute neutrophil count >1500/µL.20,49 The lymphocyte count, including lymphocyte subsets, may be reduced for a long time after exposure to the purine analogs.60 In fact, the bone marrow may require many months before recovery after treatment with a purine analog. Consequently, the standard hematologic parameters required for a complete remission are accepted at values slightly lower than normal. Therefore, it is usually recommended that an assessment for complete response with cladribine be delayed for 4 to 6 months after treatment.20,49
There should be regression of splenomegaly by physical examination. Notably, most studies have required resolution of palpable splenomegaly but have not recommended extension of treatment to resolve radiographic enlargement of the spleen. Although computed tomography scans to assess completeness of response are optional in clinical practice, these studies could be considered in the context of a clinical trial.
For more than 3 decades, complete remission was defined by morphologic criteria with the disappearance of the characteristic hairy cells from the bone marrow. Now that immunohistochemical stains and flow cytometric techniques are capable of establishing that MRD is quite evident in many patients with a normal hematoxylin and eosin stain, complete remission without MRD is also defined (Table 3). The criteria for defining a complete remission with or without MRD now includes using immunohistochemical stains (eg, CD20 and DBA.44) for the bone marrow trephine biopsy to determine the presence of residual disease. The use of VE1 as a marker for leukemic cells with the characteristic BRAFV600E mutation has also been reported to be helpful for measuring low-volume disease.39,61
Partial response
A partial response is defined by near normalization of the peripheral blood counts with a minimum of 50% improvement in both organomegaly and bone marrow biopsy infiltration with HCL. Such patients may well remain asymptomatic for many years with no further treatment. As an alternative, Dearden et al16 have administered a second course of cladribine and used rituximab in combination with a purine analog for those not achieving an optimal response with a purine analog alone. Other investigators have not opted for the second course of purine analog, but have either administered an anti-CD20 monoclonal antibody or have elected to change to an alternate purine analog to achieve the optimal response.21,59,62 Although most have acknowledged the benefit of achieving a complete response, many have advised that complete eradication of MRD, which may necessitate prolonged administration of immunosuppressive therapies, cannot presently be recommended as a well-established goal of therapy.49,63,64 Recognition that the extent of remaining MRD may have an impact on the potential for relapse must be balanced by the extent of therapy being used to achieve this end. Furthermore, some hematologists reserve further attempts at intervention for those who show either progression or persistence of symptomatic disease.
Stable disease
Patients who have not met the criteria for an objective remission after therapy are said to have stable disease. Because patients with hairy cell leukemia are treated for specific reasons, including symptoms or a decline in their hematologic parameters, stable disease is not an acceptable goal.
Progression of disease
Patients who have an increase in symptoms related to the disease or a 25% decline in their hematologic parameters qualify for progression of disease. Furthermore, a 25% increase in organomegaly based upon the nadir measurements achieved after therapy also suggests progression of disease. An effort must be made to differentiate a decline in blood counts related to the myelosuppressive effects of chemotherapy versus progression of disease. Therapy-induced myelosuppression usually follows treatment, and the patient will recover with observation.
Determination of MRD after therapy
MRD is currently defined as HCL infiltrates recognizable by immunohistochemical (IHC) stains, but not by conventional stains.29 Many hematopathologists estimate the percentage of cells on the bone marrow trephine biopsy by using an anti-CD20 monoclonal antibody or DBA.44. In patients treated with anti-CD20 monoclonal antibody, the use of this stain may be unpredictable. Therefore, application of other pan B-cell markers such as CD79a and/or HCL-specific markers (eg, VE1) or DBA.44 will be required to estimate the residual presence of hairy cells that are not detectable by regular histologic stains. One group has recommended that reliable quantitative efforts should include specific instructions for identifying the extent of MRD.63 These efforts might also be combined with assessing the value of serial soluble interleukin-2 receptor in determining the need for continuation of therapy.65,66
The risk of relapse predicted by MRD has been grouped in a single report: group I, <1% positive cells, low risk for relapse; group II, 1% to 5% positive cells by IHC, intermediate risk for relapse; and group III, >5% positive cells by IHC, higher risk for relapse. The clinical value of these predictive groups must be validated in future studies.63
Although flow cytometry has been used to quantitate the amount of residual disease in a bone marrow aspirate, these reports depend upon a consistent cellular yield. In contrast, a high-quality bone marrow biopsy provides a platform for potentially more consistent evaluation by IHC staining. Consistency in detection and reporting of MRD will be important given that hematologists may make treatment decisions on the basis of these reports. Long-term follow-up of patients in complete response will be required to determine the importance of MRD in the biopsy and/or aspirate.
Treatment at relapse
The introduction of the purine analogs has markedly improved survival in this disease. Some patients with HCL treated with purine nucleoside analogs will achieve very durable remissions that last for years without additional therapy.26,27,67 Despite this success, many patients will require re-treatment for relapsed disease (Table 4). In general, the first remission is more durable than subsequent remissions and is associated with a higher percentage of complete responders.16,68 Nevertheless, achievement of a second or greater complete remission can be accomplished with re-treatment. Review of the previous therapy should be included with consideration of a high-risk grouping. If poor-risk features were identified (eg, severe anemia, spleen >10 cm below the left costal margin, atypical immunophenotypic profile, mutation of p53, IGHV4-34+ rearrangement, unmutated IGHV, absence of BRAFV600E mutation), identification of an underlying explanation for a less-than-desired initial response may be helpful in deciding whether to pursue investigational therapies.3,6,12 Although posttreatment bone marrow biopsies are not mandatory outside a trial, they are required to document a complete remission (information that carries considerable prognostic information), and are quite useful even in routine practice. Therefore, a bone marrow biopsy is absolutely necessary to document a complete remission.
Criteria for re-treatment at relapse are equivalent to the initial criteria, including symptomatic disease (eg, splenomegaly) or progressive anemia, thrombocytopenia, or neutropenia.20,49 In general, patients with an initial remission of <24 months should consider alternative therapy, including investigational agents and regimens, after confirming the accuracy of the original diagnosis. Other therapeutic approaches may still offer benefit for selected patients (eg, interferon alpha, rituximab, splenectomy). Considering the success of newer agents, enrollment in a clinical trial is also an important option.
Finally, the decision of when to re-treat a patient whose disease is relapsing requires judgment. The mere reappearance of hairy cells either in the peripheral blood or the bone marrow by morphologic or immunophenotypic/immunohistochemical techniques must be carefully weighed considering the potential toxicity of immunosuppressive therapy. The re-demonstration of leukemic cells may indicate that a complete response has ended, but the clinical definition of relapse requiring re-treatment is based upon recurrence of disease-related symptoms (eg, symptomatic splenomegaly) or deterioration in hematologic parameters (eg, absolute neutropenia, progressive thrombocytopenia, or anemia) equivalent to the values initially used for beginning treatment. Establishing the trend of progressive pancytopenia is important, but good clinical judgment would indicate that attempts to re-treat should begin before these values have deteriorated to low levels.
Consideration for investigational approaches
Recognition of the presence of the BRAFV600E mutation led to trials that showed response to small molecule inhibitors of this target.5,46 Complete remissions have been reported after using the BRAF inhibitor vemurafenib in relapsed and refractory disease.42-45,69 The duration of these remissions is currently being defined in well-designed clinical trials. However, relapse is a frequent finding, and thus strategic combinations and/or alternative schedules of administration will need to be pursued.46 Furthermore, newer targeted inhibitors of BRAF (eg, dabrafenib) also show promise in relapsed disease, thus meriting study in larger clinical trials.8,41,70 These agents have enabled improvement in absolute neutrophils, which shows promise for patients with life-threatening infection. The role of vemurafenib in treating patients with hairy cell leukemia and infection deserves careful attention.58 It is important to recognize adverse effects from the BRAF inhibitors that may include skin rash, arthralgias, arthritis, or secondary skin tumors that necessitate follow-up with a dermatologist. Rarely, vemurafenib has caused abnormal renal function.46
Ibrutinib, a first-in-class oral inhibitor of the Bruton tyrosine kinase has recently been approved for treating patients with relapsed or refractory B-cell malignancies.71 This agent is currently under study in a National Cancer Institute–sponsored multi-institutional trial for patients with HCL who have not achieved optimal response to standard therapies.
Immunotoxin conjugates have been developed at the National Institutes of Health and are now being investigated in multi-institutional clinical trials (eg, HA-22 or moxetumomab pasudotox).72,73
There are many opportunities for evaluating novel agents alone or in strategic combinations.74 Because we have prolonged the projected survival for these patients, recurrent relapse can be anticipated, which merits continued investigation.
Infection prevention and treatment
The most frequent cause of death among patients with HCL is infection. Because these patients often present with pre-existing neutropenia and/or monocytopenia, bacterial, viral, and opportunistic infections should be anticipated. In addition, the primary therapy for HCL is immunosuppressive, and patients may be placed at further risk for infection during treatment. Purine analogs confer prolonged suppression of immune effector cells (eg, CD4+ T cells) and induce profound and prolonged neutropenia.75
Patients must be educated about preventing infection and must learn the indications for seeking medical treatment (eg, fever during periods of neutropenia, rash consistent with varicella zoster). Evidence for the use of specific prevention strategies has not been validated in well-controlled clinical trials. Practice patterns vary among groups, and thus evaluation of prevention and treatment strategies is an important area of needed research.20,49,76
The use of myeloid growth factors needs to be considered on a case-by-case basis in patients with active infection.20 Patients may receive vaccinations that use killed viral agents, but there are no data showing that patients with this disease respond to vaccines . Live virus vaccines should be avoided.
Because patients with HCL who have previously been treated with purine analogs have profound and persistent lymphopenia, they should probably receive irradiated blood products, if a transfusion is indicated, to prevent transfusion-associated graft-versus-host disease. Furthermore, hepatitis history should be documented with consideration for suppressive anti-viral treatment of those who are positive for hepatitis B surface antigen. Patients have had severe liver toxicity after immunosuppressive therapy if there is a chance that reactivation of viral hepatitis should occur. Therefore, screening for previous exposure to hepatitis before therapy for the disease is highly recommended.77
Summary
Enormous progress in the management of HCL has resulted in prolonged survival in many patients. HCL cannot be cured with standard chemoimmunotherapy, and patients remain at risk for relapse over time. Because of the tremendous success of standard therapy, many patients are now treated outside clinical trials; thus, there is increasing variability in disease management and monitoring. The Hairy Cell Leukemia Foundation convened an international conference to provide common definitions and structure to guide disease management. The development of consensus guidelines for this rare disease offers a framework for continued improvement of outcomes for these patients.
Patients should be encouraged to follow normal recommendations for cancer screening, including routine careful follow-up with a dermatologist. Studies in patients with chronic lymphocytic leukemia show that an immune response to vaccinations is limited.78 Because infection is a leading cause of morbidity and mortality in both chronic lymphocytic leukemia and HCL, further investigation of the effectiveness of vaccination strategies to prevent illness is warranted. The development of these consensus guidelines is intended to improve the care of patients with this uncommon hematologic malignancy by addressing the most common complications. Patients with HCLc can also have many unusual manifestations of the disease. The guidelines are intended to enhance care of patients and should not be used to deny appropriate and necessary diagnostic or therapeutic interventions.
Authorship
Contribution: All authors participated in the development of these guidelines through extensive discussion at an international meeting with extensive revision of the manuscript after the meeting. The International Hairy Cell Leukemia Research Foundation sponsored the meeting. M.R.G. drafted the manuscript; M.R.G. and B.F. revised the manuscript with contributions from each of the authors; and all authors contributed revisions and approved this manuscript.
Conflict-of-interest disclosure: L.A.A. received research support from Sanofi; V.B. consulted for Roche, Lundbeck, Gilead, and Janssen (all related to chronic lymphocytic leukemia); C.D. is on an advisory board/receives honoraria from Roche, Medimmune, Gilead, Janssen, and AbbVie; B.F. along with E.T. filed a patent on the discovery of BRAF mutation in hairy cell leukemia and received research funding from Roche; F.F. is on an advisory board for Infinity and has received honoraria from Gilead, AbbVie, and Janssen; M.R.G. serves on an advisory board regarding ibrutinib for Pharmacyclics and a data safety monitoring board for Acerta; A.D.H. serves on an advisory committee/board for Daimler and Benz Foundation and for Genzyme-Sanofi and Roche and has received research funding from Sanofi; J.J. has received research funding and drugs (ibrutinib) from Pharmacyclics for a hairy cell leukemia clinical trial; G.J. has advised Merck and EMD Serono regarding cladribine in multiple sclerosis; S.A.P. has received research funding from Pharmacyclics; F.R. has received research funding from MedImmune; J.F.S. has received honoraria and travel support from and participated in a speaker’s bureau for Roche; C.T. has received honorarium and research funding from Janssen-Cilag and AbbVie; X.T. had research funding from Roche and received honoraria or served as advisor or consultant for Roche and Gilead; C.S.Z. had research funding from GlaxoSmithKline, Novartis, Genzyme, and Biothera; P.L.Z. has consulted for Bayer AG, Sandoz, and Morphosis; has participated in a speaker’s bureau for Celgene, Pfizer, Takeda, Gilead, Janssen, and Teva; has received honoraria from Celgene, Roche, Teva, Gilead, Janssen, Takeda, and Pfizer; and has participated in advisory boards for Bayer AG, Celgene, Roche, Gilead, Janssen, Takeda, and TG Pharmaceuticals. The remaining authors declare no competing financial interests.
Correspondence: Michael R. Grever, Division of Hematology, Department of Internal Medicine, The Ohio State University James Cancer Hospital, 395 W. 12th Ave, Room 392, Columbus, OH 43210; e-mail: michael.grever@osumc.edu.